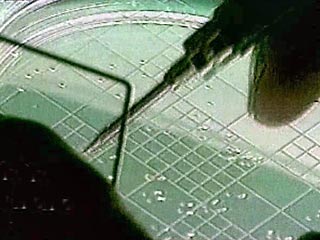

The Guardian: Советская программа разработки биологического оружия в Азии оставила смертельное наследие
Британская пресса в четверг рассуждает о потенциальной угрозе, которую представляет наследие холодной войны. Журналист The Guardian побывал на бывшем советском полигоне для испытаний биологического оружия, действовавший на острове Возрождения в центре высыхающего Аральского моря. Там до 1992 года располагался один из самых секретных и опасных военных объектов бывшего Советского Союза, известный узкому кругу лиц как "Аральск-7".
Пустынность и изолированность этого места как нигде подходила для секретных операций. Остров, расположенный в 3,5 тысячах километров от Москвы, посреди моря, окруженного малонаселенной пустыней в сердце Центральной Азии, был хорошей площадкой для испытания смертельных микробов. Название этого острова - остров Возрождения - отдает горькой иронией.
На острове проводились испытания биологического оружия, превращавшие в оружие массового уничтожения бактерии чумы, сибирской язвы и оспы, а также туляремии, ботулизма, лихорадки и венесуэльского лошадиного энцефалита. Некоторые бактерии генетически модифицировались для создания устойчивости к существующим медикаментам.
Подходы к острову охранял от непрошеных гостей морской патруль. Считалось, что остров отделяет от материка достаточно большое расстояние, что позволяет не допустить распространения биологических веществ на "материк".
Но теперь это не так, пишет The Guardian, перевод статьи которой публикует сайт Inopressa.ru. Аральское море за последние 50 лет обмелело, истощенное ирригационными системами. Уровень моря понизился, а площадь острова увеличилась. В 1960 году площадь острова была около 200 квадратных километров, сегодня - в 10 раз больше. Фактически остров Возрождения больше не является островом, так как соединен полоской суши с материком, с территорией Узбекистана.
Британский журналист добрался на "остров" в сопровождении проводников на машине по суше. И далее по длинной прямой дороге из бетонных плит к брошенному военному городку. Этот военный городок на острове в Аральском море построен в 1954 году, в нем жила тысяча человек – ученые, сотрудники служб безопасности и их семьи.
Теперь же на окраине заброшенного военного городка ржавеет свалка автомобилей и другой техники, на которой сквозь ржавчину можно различить надписи белыми буквами. Ландшафт неровный, много неглубоких оврагов. В одном из них много брошенных боеприпасов, из земли торчат гильзы от снарядов и наконечники ракет.
Власти Казахстана и Узбекистана, в собственности которых находится остров, посещать его не рекомендуют. Несмотря на то, что почти все биологические вещества, которые испытывались на Возрождении, быстро разрушаются при ультрафиолетовом излучении. Возможность того, что патогенные микроорганизмы могли выжить на острове, минимальна: скудная растительность острова, жаркий пустынный климат и песчаная почва, которая летом прогревается до температуры 60 градусов Цельсия, - все это убивает бактерии. Кроме бактерий сибирской язвы, которые являются наиболее устойчивыми: они могут сохраняться в почве очень долгое время, и при их попадании в легкие человека вероятность смертельного исхода составляет 90%, отмечает The Guardian.
После терактов в США 11 сентября 2001 года остров посетила группа американцев. Они хотели воочию удостовериться в том, что террористы не смогут найти на нем ничего такого, что они могли бы использовать для достижения своих зловещих целей. "Но никто из тех, с кем я разговаривал в Казахстане, не знает точно, что делали американцы на острове, - утверждает британский журналист. - Между тем один эксперт рассказал мне, что на обеззараживание британского острова Грюнард, на котором во время Второй мировой войны прошло несколько испытаний биологического оружия, ушло 40 лет. Им пришлось залить весь остров формальдегидом, чтобы убить каждую бактерию, ведь эти бактерии могут сохраняться сотни лет".
Свои впечатления от посещения бывшей секретной советской базы журналист The Guardian сформулировал так: "Когда я был на острове, я остановился и на мгновение прислушался. Никаких звуков, никакого пения птиц. Только зловещая тишина. Это поистине смертельная тишина. Парадокс для места, которое называется остров Возрождения".